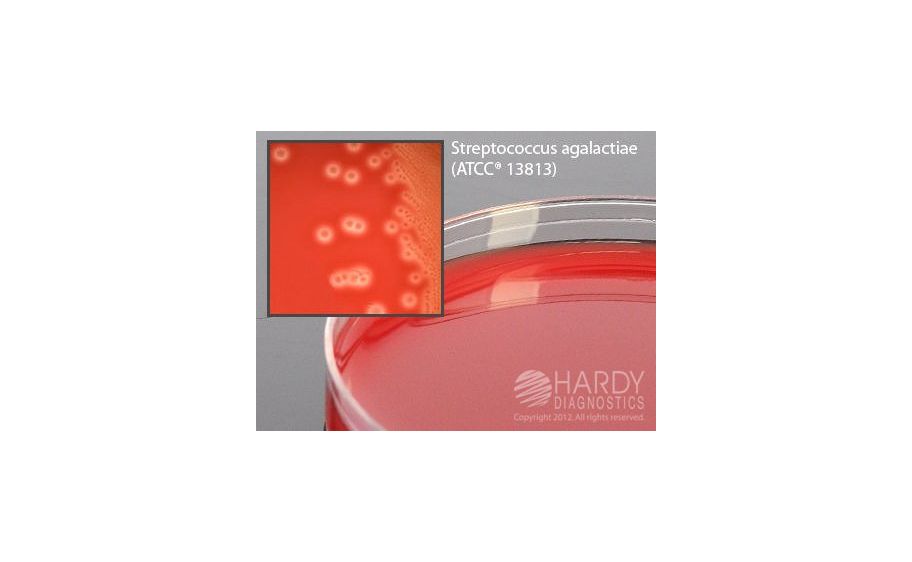
main product photo

Need Help?
800-229-7252

GBS DETECT GROUP B STREP 15X100MM 10/PK
1
/
PK
Lead Time
12 Day(s)
SKU
VWR76288-444-PK
MFRPN
GA300
GBS DETECT GROUP B STREP 15X100MM 10/PK
Gbs Detect Group B Strep 15X100Mm 10/PK GBS DetectGΣ≤, For non-hemolytic Group B Strep, Reduced stacking ring for automated inoculating devices, Isolation and differentiation by enhanced hemolysis of gamma hemolytic Group B Streptococcus, Work smoothly with automated streaking devices, 15x100mm plate
| Manufacturer | Hardy Diagnostics |
|---|---|
| MFRPN | GA300 |
| Lead Time | 12 Day(s) |
| UNSPSC Code | 12000000 |
Write Your Own Review